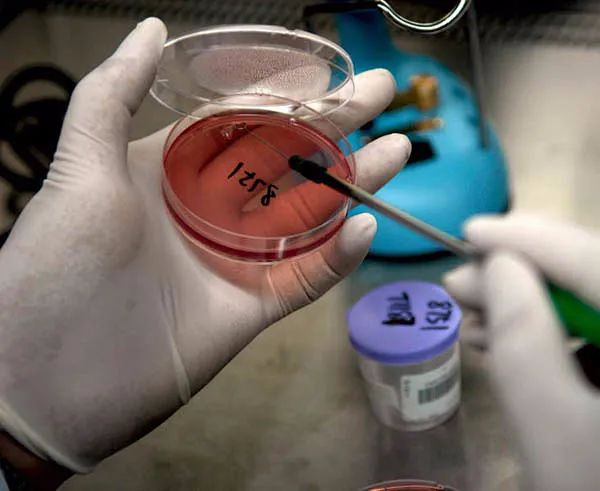
全面解析丨菌落总数检测知识汇总,新手必看~

广东环凯生物科技有限公司品牌商
5 年
手机商铺
- NaN
- 0.20000000000000018
- 1.2000000000000002
- 0.20000000000000018
- 3.2
推荐产品
公司新闻/正文
全面解析丨菌落总数检测知识汇总,新手必看~
697 人阅读发布时间:2022-12-14 10:31
菌落总数是评价食品卫生质量的重要指标,其检测工作在某种程度上具有相当的不可比性,这就要求检测人员要严格执行科学的操作程序。国家标准GB4789.2中只是简要提到了检测程序,对实际操作过程中容易出现的问题未作详细说明。本文就检测中容易出现的问题,作一阐述。

01 菌落总数所使用的标准
在食品企业一般会用到的两个做菌落总数的标准。(当然还有其他的标准)
食品国家标准:GB 4789.2-2016 《食品安全国家标准 食品微生物学检验 菌落总数测定》(2022版即将实施)
生产用水:GB-T5750.12-2006 《生活饮用水标准检验方法微生物指标》
以上两个标准检测方法差不多,区别在于:食品的培养基是使用PCA、菌落总数测试片(应符合GB4789.28中平板计数琼脂培基质量控制要求,且主要营养成分与平板计数琼脂培养基配方一致。2022版新增内容),生产用水的使用NA。
02 培养基成分

03 检测方法
1、传统的检测方法操作流程:

2、计数要点
(1).可用肉眼观察,必要时用放大镜或菌落计数器,记录稀释倍数和相应的菌落数量。菌落计数以菌落形成单位(colony-formingunits , CFU )表示。
(2).选取菌落数在 30CFU~300CFU 之间、无蔓延菌落生长的平板计数菌落总数。低于 30CFU的平板记录具体菌落数,大于 300CFU 的可记录为多不可计。每个稀释度的菌落数应采用两个平板的平均数。
(3).其中一个平板有较大片状菌落生长时,则不宜采用,而应以无片状菌落生长的平板作为该稀释度的菌落数;若片状菌落不到平板的一半,而其余一半中菌落分布又很均匀,即可计算半个平板后乘以2,代表一个平板菌落数。(这个是很多新手会问的一个问题)
(4)当平板上出现菌落间无明显界线的链状生长时,则将每条单链作为一个菌落计数。
3、操作细节
(1). 菌落总数是比较常规的微生物检测项目,也是比较容易做的一个微生物检测方法,主要注意无菌操作,与稀释液均匀性。
(2). 在空白出现菌落的时候需要去分析哪一步出现问题,人、机、料、法、环。当然空白出现菌落的时候,那么该批次的菌落总数数据都作废处理。在制样和做样的时候需要在百级的环境(百级的洁净工作台)下进行。
(3). 稀释液的均匀性,这个会影响结果。刚开始的时候可能会造成同一梯度的两个结果相差较远,这是因为做的时候没有把稀释液均匀。如果前后两个梯度没有梯度性,那么就是在做稀释做不好。这个都是靠多做,技术才会提高的。(当然还有一种情况,样品是中添加了抑菌物质,也会导致没有梯度性。)
04 结果计数
(1). 若只有一个稀释度平板上的菌落数在适宜计数范围内,计算两个平板菌落数的平均值,再将平均值乘以相应稀释倍数,作为每g(mL)样品中菌落总数结果。

(2). 若有两个连续稀释度的平板菌落数在适宜计数范围内时,按式( 1 )计算:


(3). 若所有稀释度的平板上菌落数均大于300CFU ,则对稀释度最高的平板进行计数,其他平板可记录为多不可计,结果按平均菌落数乘以最高稀释倍数计算。

(4). 若所有稀释度的平板菌落数均小于30CFU ,则应按稀释度最低的平均菌落数乘以稀释倍数计算。

(5). 若所有稀释度(包括液体样品原液)平板均无菌落生长,则以小于 1 乘以最低稀释倍数计算。

(6). 若所有稀释度的平板菌落数均不在30CFU~300CFU 之间,其中一部分小于 30CFU或大于300CFU时,则以最接近30CFU 或 300CFU 的平均菌落数乘以稀释倍数计算。

05 菌落总数的问题(新手疑答)
1 有新人可能会拿着菌落总数的平板去问别人这是什么菌?
这是看不出来的,菌落总数只能检测出样品卫生情况,一个样品的细菌数量,不能验证出什么菌。这是一个不应该犯的误区。
2 在做菌落总数时,样品和菌落如何区分?
方法1:在培养基中添加TTC(一般2%浓度1mL加到400mL的培养基中,TTC的浓度不要过高,会有抑制作用)。TTC的原理:TTC和活细胞线粒体内的琥珀酸脱氢酶反应,生成红色的甲臜。那么生长的菌落会变成红色,这样就可以区分菌落与样品。
方法2:4℃冷藏保存一个样品和培养基混匀的平板做对照,观察菌落的形态特征去区分。
3 培养后的培养基出现干裂情况是怎么回事?
干裂是由于培养基里面的水份缺失导致,所以当出现干裂情况,先要观察干裂平板的数量和位置。看是否是培养箱内部温度不稳定导致(一般平皿一叠可以放置六个,同时要注意每叠之间需要保留一点间隙让其通风);排除仪器的原因之后,看是培养基是否倒得太薄(初学者可以拿三角瓶装水进行练习);还有其他原因,其实在出现干裂的情况下,结果是无效的(除非干裂情况不严重)。排查出问题所在,可以避免我们下次再犯错。
4 培养基的配置
方法1:用一个大容器配置培养基,然后加水煮热溶解(注意搅拌,防止烧焦),待溶解完成之后进行分装(这里需要注意安全),再去灭菌。
方法2:使用500mL三角瓶(其他容器也可以)配置300ml的培养基,加水稍微溶解(此步不需要加热),再拿去灭菌。
5 若所有稀释度的平板菌落数均不在 30CFU~300CFU 之间,其中一部分小于 30CFU 或大于300CFU 时。就会有人不知道怎么去判定那个梯度更接近30-300?举例:一个梯度:28/28;另梯度:305/305,那么那个数据更接近呢?
恢复为同稀释度做差比较:把两个梯度换算成同一个梯度,一般把28换算成280。280-300=-20,相差20;305-300=5,相差5。20比5要大,那么采取305相应的梯度。
6 最低稀释梯度中一个平板出现1个菌落,另一个无菌落生长。那么结果怎么出呢?
(以固态为例子)在过去也有讨论过,有人认为报告写5,也有认为报告写<10(比较两个平板均无菌落生长的时候报<10)这个两个报告方法其实也是可以采用。(我是采用第一种;个人理解不长报告<10,那么长了也报<10吗?不太合理)。

菌落总数是微生物检测中最常见的项目,在检验的每一个环节都应该小心谨慎,精准操作,确保检测结果的准确度。因此,只有检测人员严格按要求进行实际操作,避免产生错误,才能保证科学、准确地得出符合样品实际的检测结果。
文章来源食品论坛网友微生物人员原创分享。
提醒:文章、视频、图片等所有内容,仅用于学习交流,若有侵权内容及其他涉法内容,请及时联系删除或修改。特此声明!






